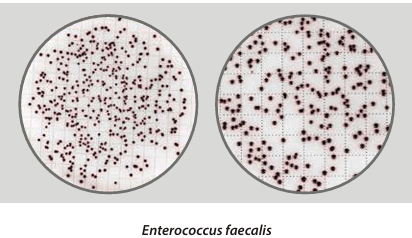
Easy Dry Bile Aesculin Azide - Kormay Biomedicals store
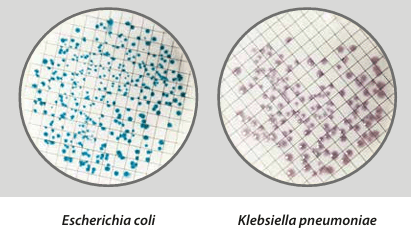
Easy Dry Chromatic Coli Coliform - Kormay Biomedicals store
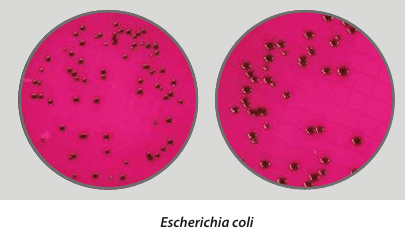
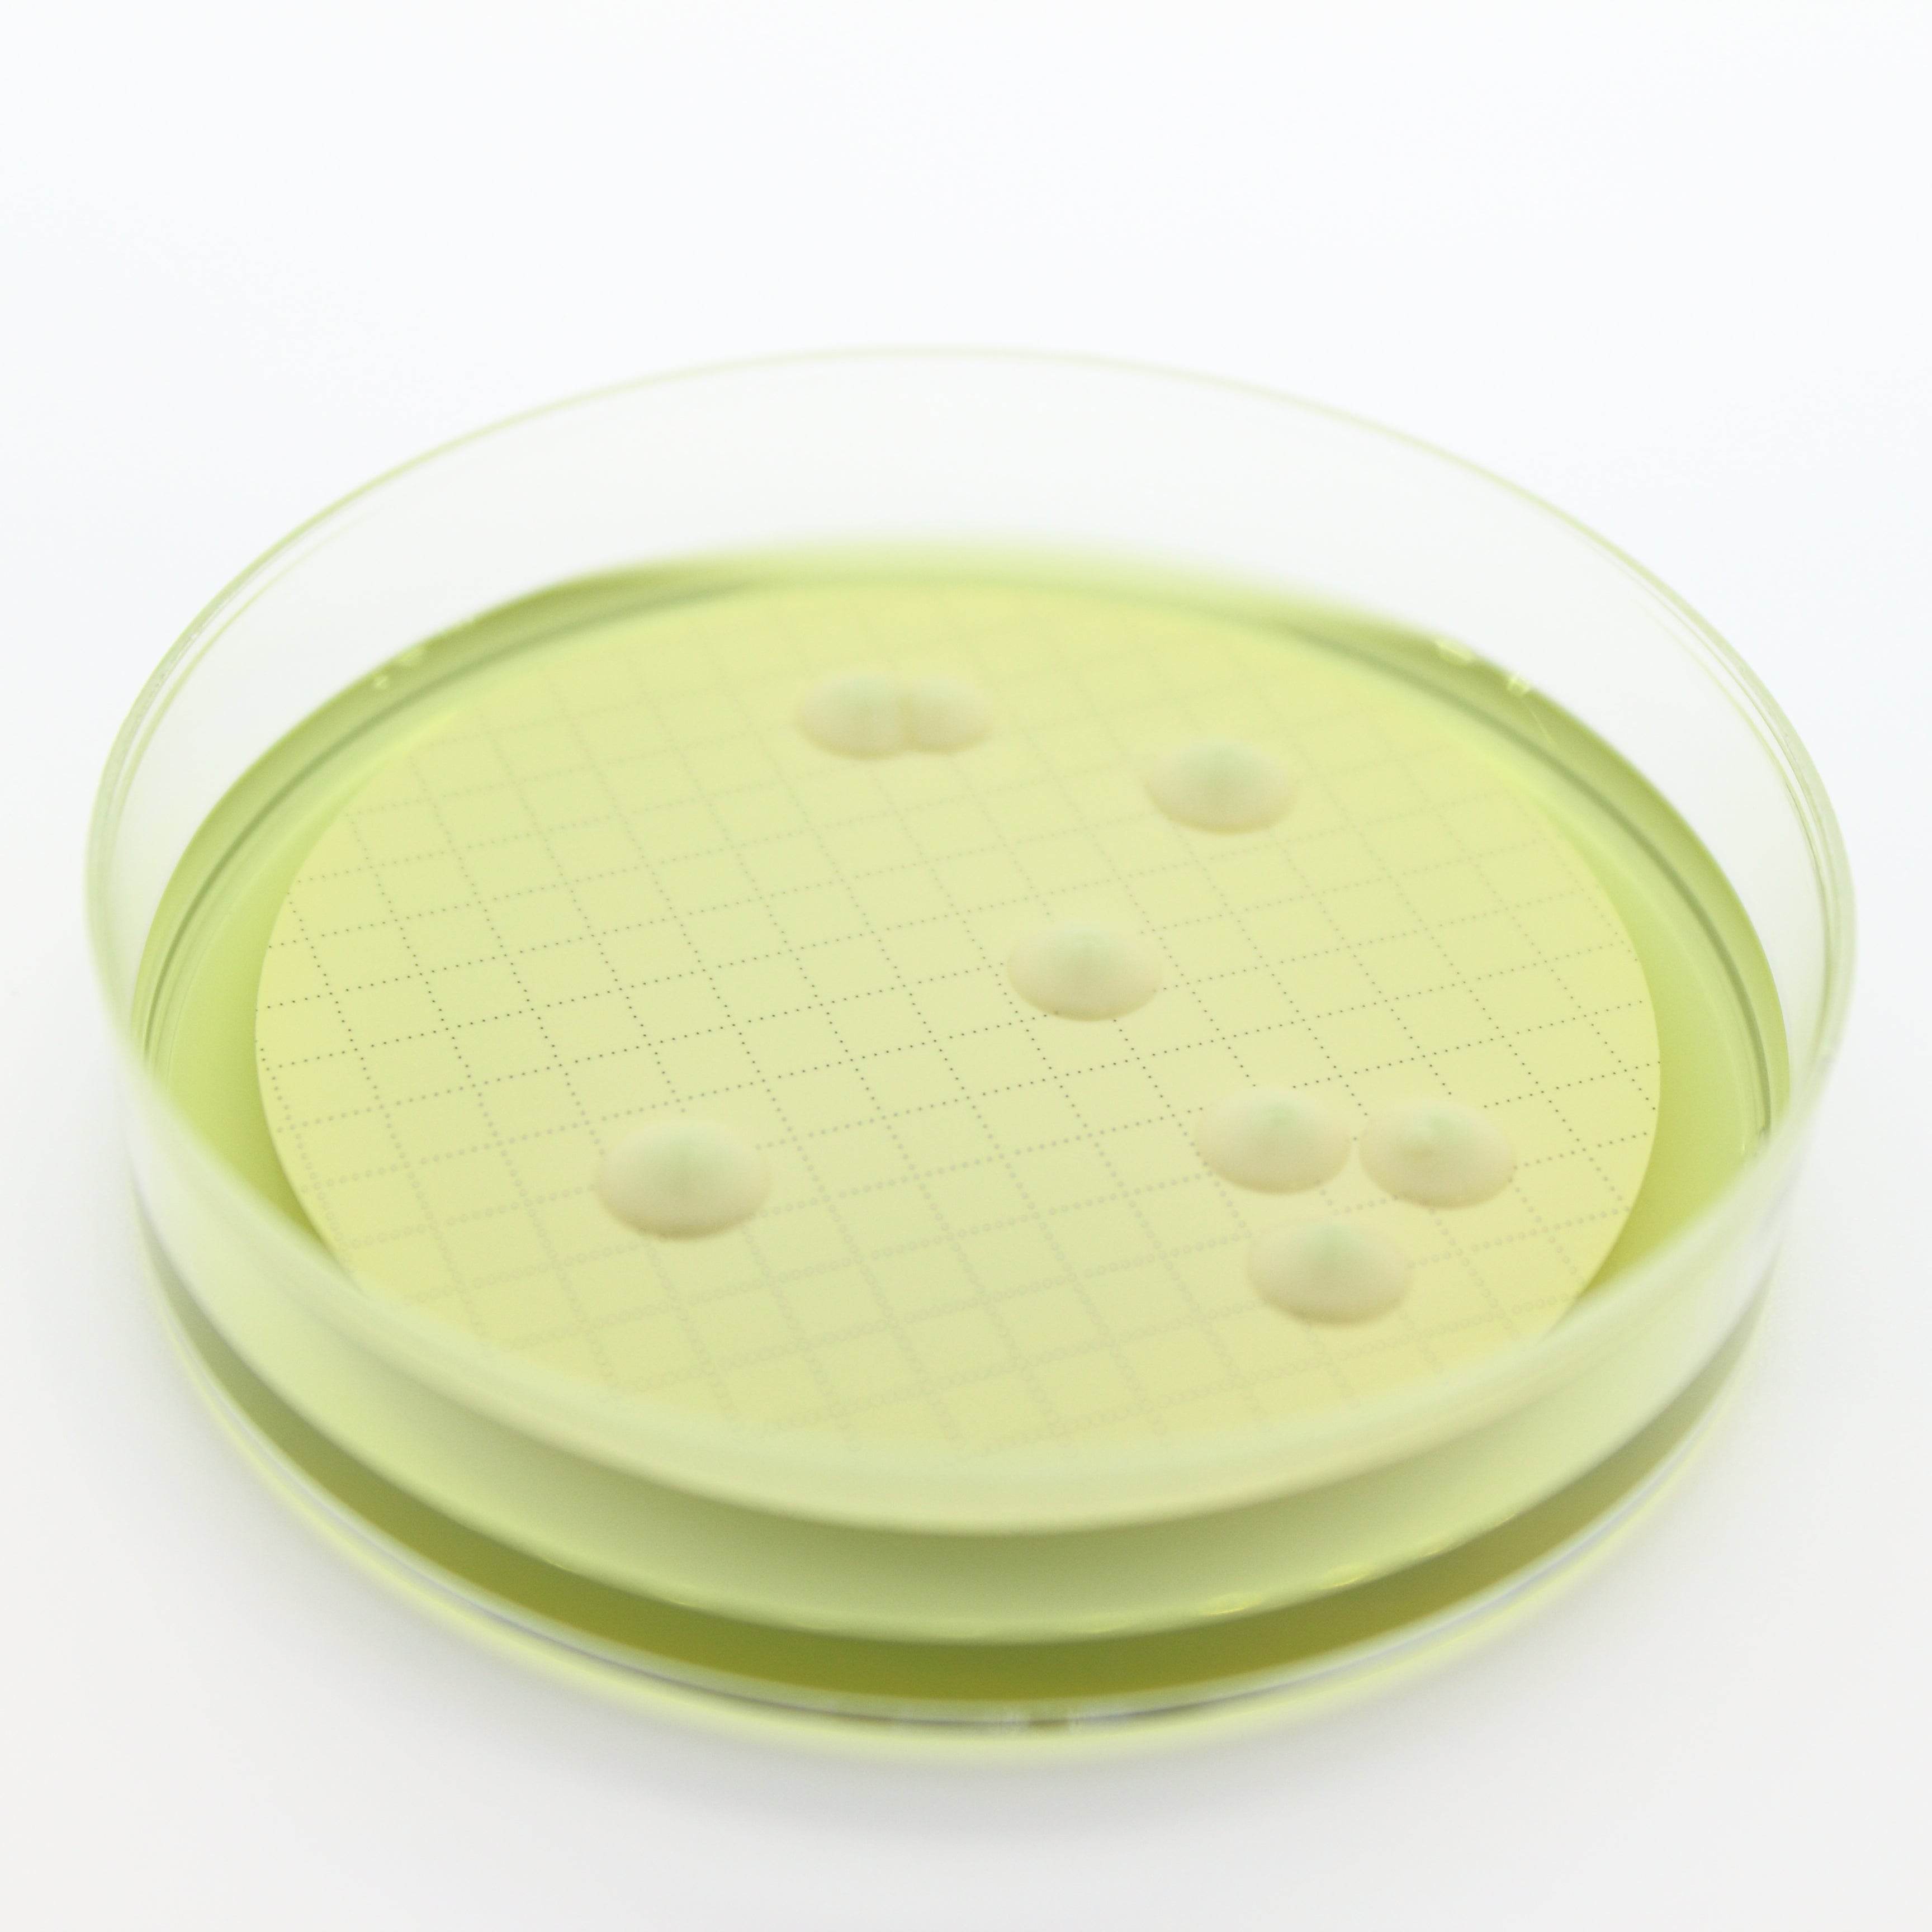
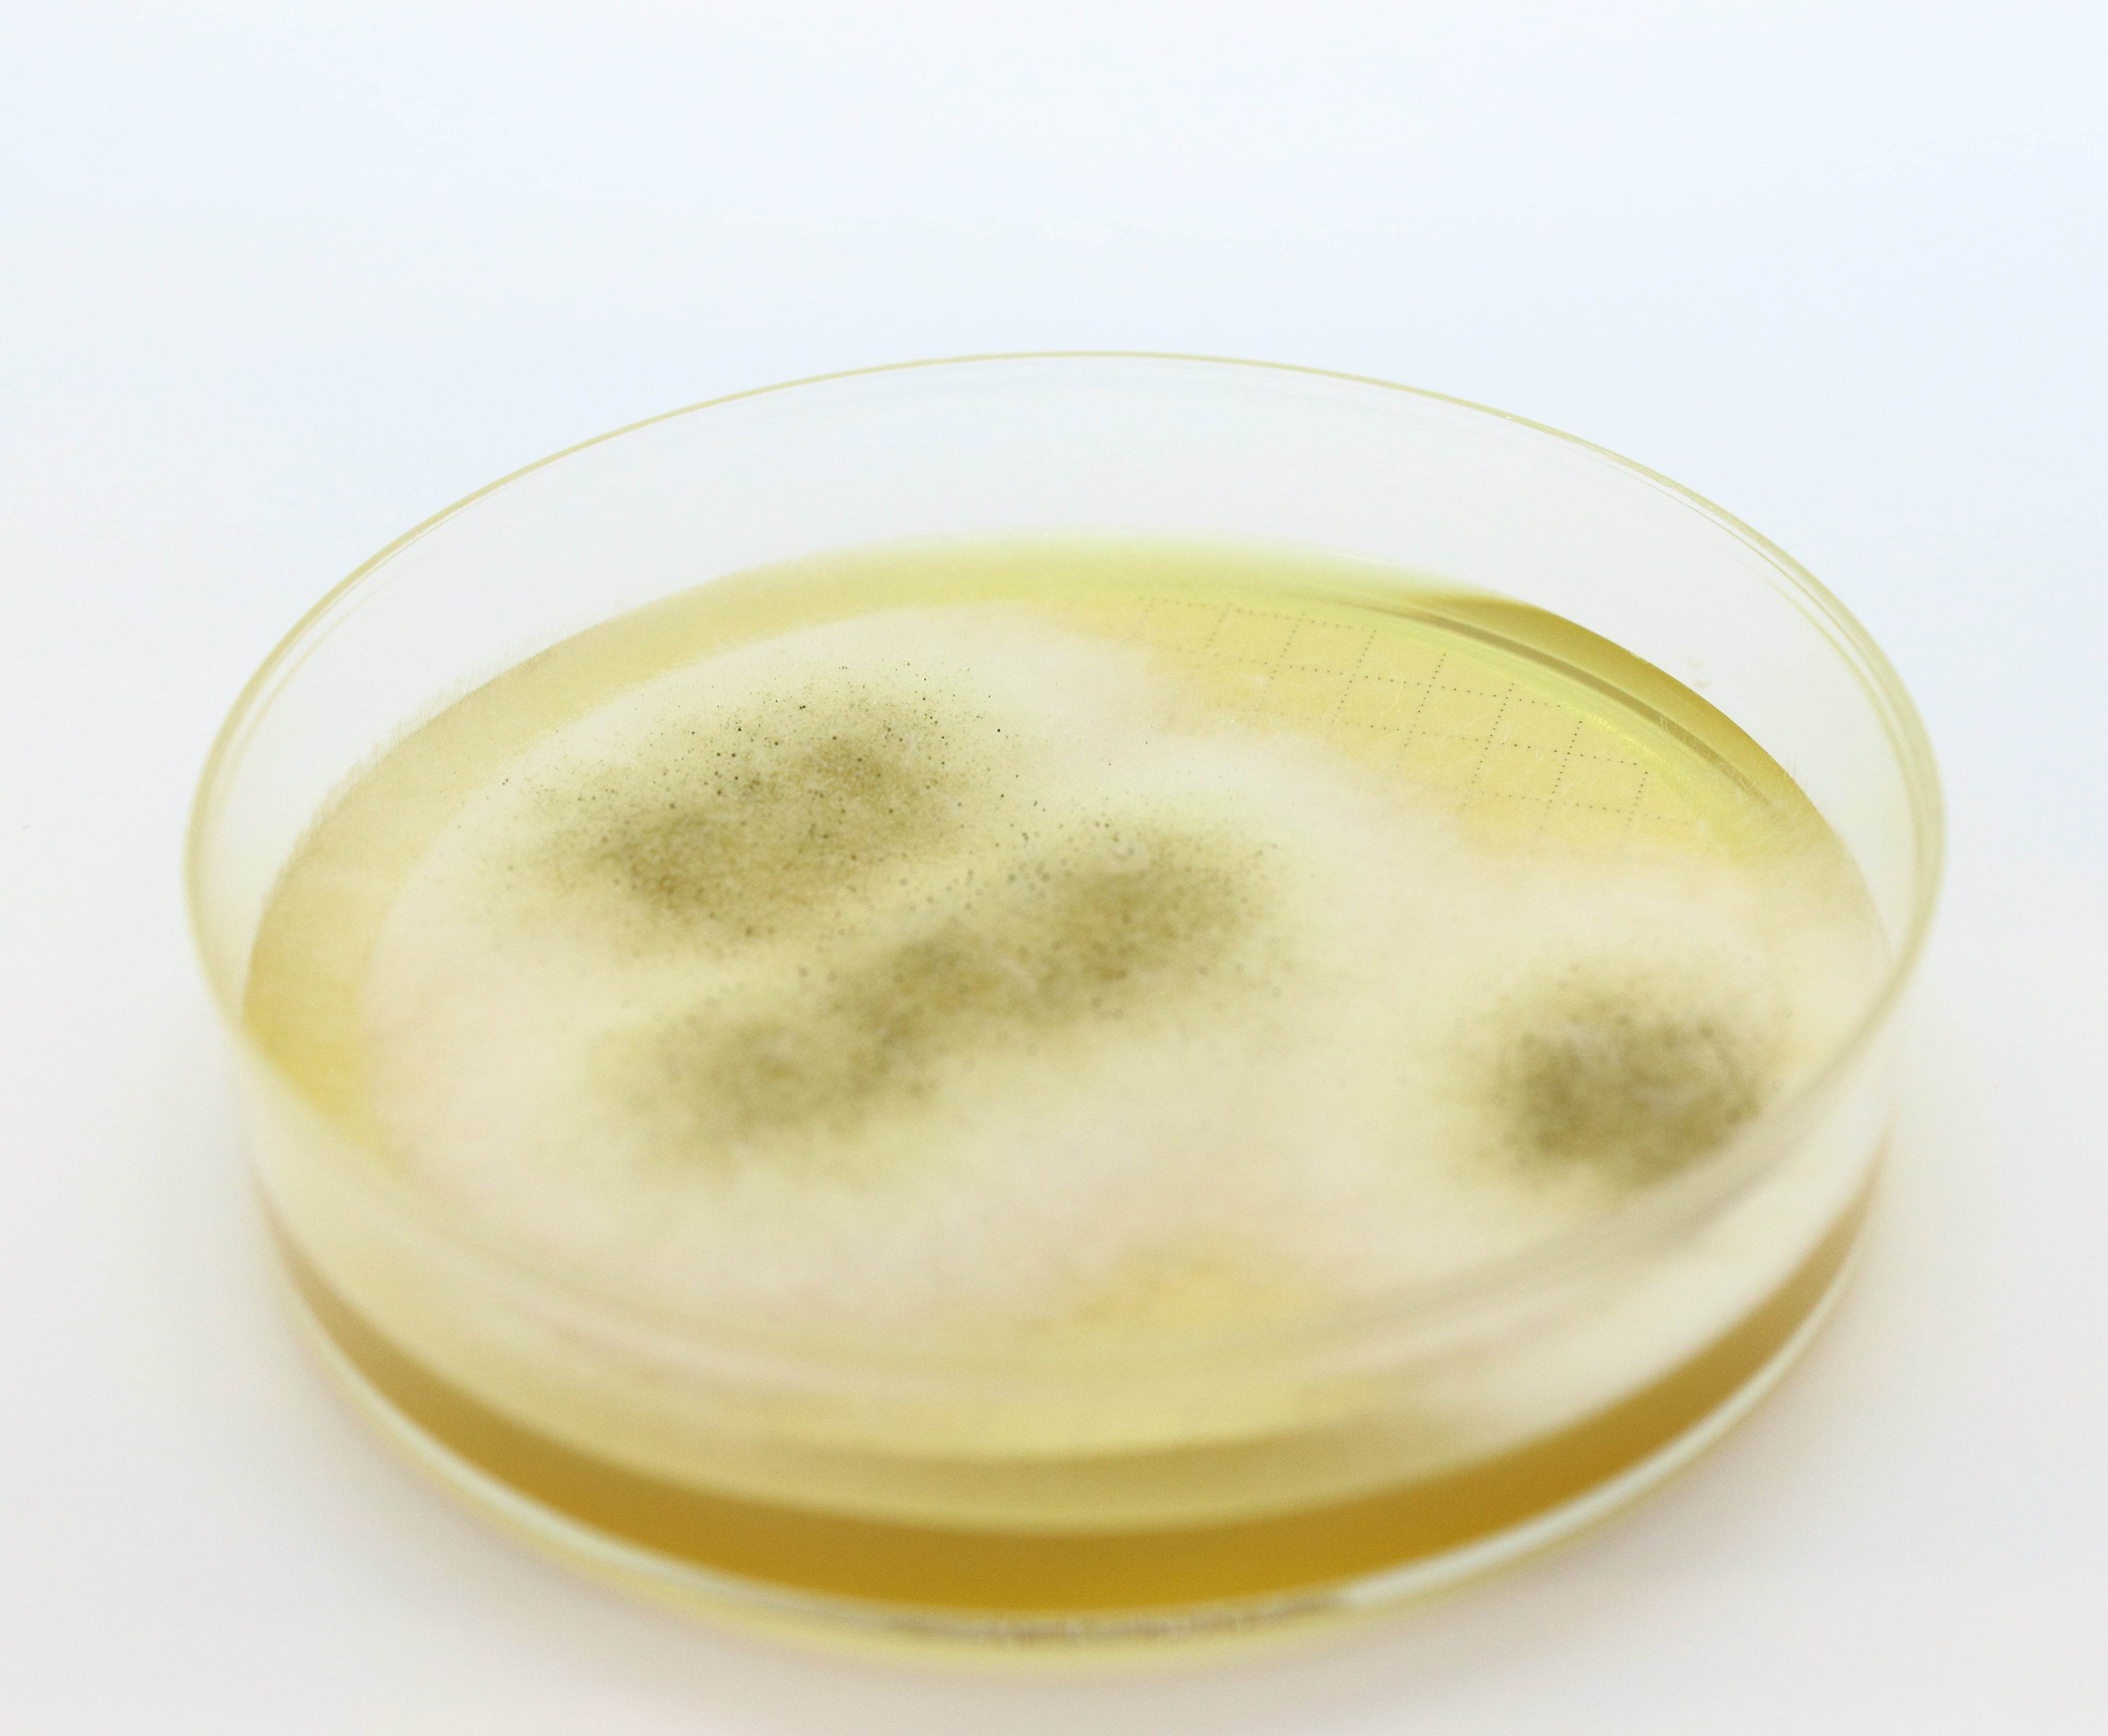

Microbiology Media & AST
Shop Microbiology Media & AST products for clinical diagnostics, food safety, and research, including antibiotic discs and culture media.
Showing 289 - 312 of 996 products
Display
View


Liofilchem
AST DISC Dicloxacillin DCX 1 µg - Microbiology Testing Disc (lab use only)
Sale priceFrom $68.00 CAD


Liofilchem
AST DISC Dipicolinic Acid DP - Microbiology Testing Disc (lab use only)
Sale priceFrom $68.00 CAD


Liofilchem
AST DISC Doripenem DOR 10 µg - Microbiology Testing Disc (lab use only)
Sale priceFrom $68.00 CAD


Liofilchem
AST DISC Doxycycline DXT 30 µg - Microbiology Testing Disc (lab use only)
Sale priceFrom $68.00 CAD
Filters (0)